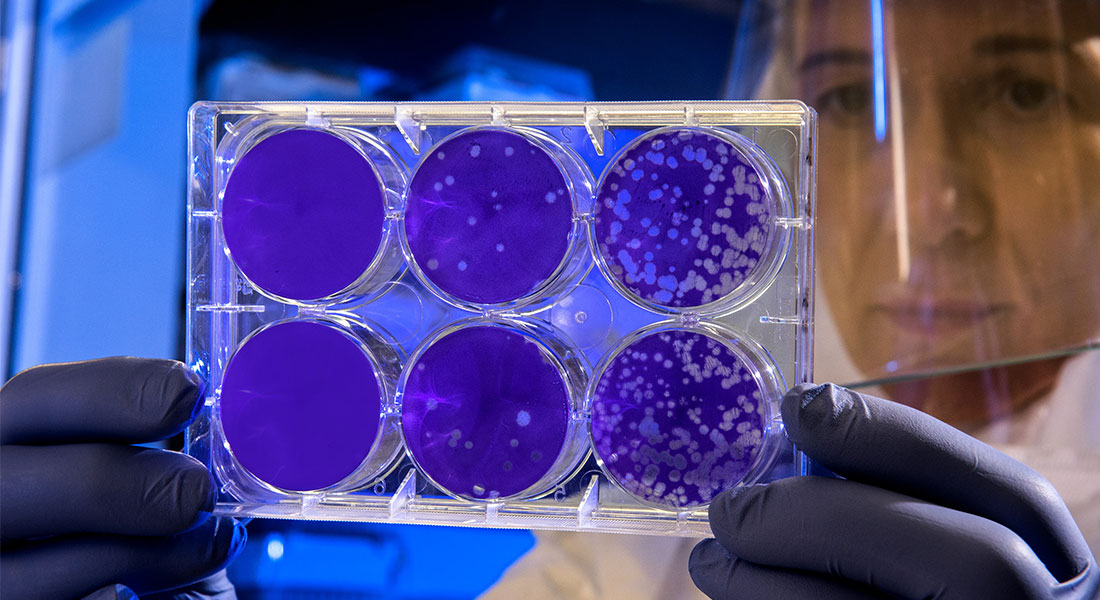
Promega Lab Blog - Senescenza cellulare e terapie oncologiche: superare l'immortalità 3

Articoli correlati
Storia ed evoluzione della ricerca sull'MSI ›
Notice: Promega will be performing essential system updates January 21–25.
Order processing and shipping will pause starting January 21 at 4:00 PM CST and resume on January 26.
Please plan to order in advance for any products needed during this timeframe.
Please contact Customer Service with any questions.
Grazie per aver verificato il tuo indirizzo email.
C'è stato un errore nella verifica dell'indirizzo email. Riprova o contatta il servizio clienti
28.11.22 – Articolo di Kenn Doyle, traduzione di Giacomo Grisafi

Per quanto sia il sogno di molti, ad oggi nessuno scienziato è ancora riuscito a scoprire il segreto dell'immortalità, sempre che ne esista uno. Fin dall'antichità, a dispetto degli sviluppi tecnologici, ci siamo abituati a quello che viene definito "ciclo della vita". Si nasce, si invecchia e si muore. Non ci sono altre opzioni.
Ma questa ineluttabile verità non ha mai impedito agli scienziati di credere come, il ciclo della vita, possa non valere per le nostre cellule in coltura. Parliamo, potenzialmente, di immortalità cellulare, con cellule in grado, se fornite delle adeguate sostanze nutritive, di crescere e proliferare per sempre.
Un pionieristico studio pubblicato nel 1961 da Leonard Hayflick e Paul Moorhead ha sfidato questa teoria (1). Secondo la loro ricerca, le cellule in coltura hanno una capacità finita di replicarsi e, al raggiungimento di un certo numero di cicli replicativi, smettono di dividersi. Vi è però un importante postulato nello studio di Hayflick e Moorhead. I due hanno infatti fatto l'importante distinzione tra cellule normali e cellule tumorali. Queste ultime, in coltura, sarebbero veramente immortali. Negli anni successivi a questa ricerca, il limite del numero di cicli replicativi che le normali cellule umane possono eseguire divenne noto come limite di Hayflick. Sebbene alcuni scienziati esprimano ancora scetticismo su questi risultati, il limite di Hayflick è ampiamente riconosciuto come un principio fondamentale della biologia cellulare.
Cosa succede alle cellule una volta raggiunto il limite di Hayflick? In via generale, entrano in uno stato di senescenza cellulare, in cui la crescita viene arrestata e le cellule smettono di dividersi. Questo fenomeno non è limitato alle cellule coltivate in laboratorio, ma accade anche all'interno degli organismi viventi. Sebbene possa far parte del normale processo di sviluppo, la senescenza è solitamente innescata quale risposta a fattori di stress. Esempi comuni includono danni al DNA causati dall'esposizione a radiazioni o sostanze chimiche tossiche, lesioni ai tessuti o disturbi metabolici (2), oltre che da lesioni oncologiche. Poiché le cellule senescenti non possono più proliferare, questa risposta può agire come un potente meccanismo di soppressione del tumore (3).

Il fine ciclo delle linee cellulari è la morte cellulare programmata o apoptosi, un processo strettamente controllato e avviato da una via che può essere intrinseca o estrinseca. All'interno di questo processo, un ruolo chiave è quello giocato dalle caspasi, che portano alla degradazione delle proteine e alla morte cellulare. Ma non è raro che le cellule senescenti mostrino una caratteristica resistenza all'apoptosi (4).
Le cellule senescenti presentano, rispetto alle cellule proliferanti, una morfologia caratteristica e una tipica espressione genica (4). A livello proteico, questi complessi cambiamenti determinano la secrezione di citochine infiammatorie, chemochine, fattori di crescita e altre molecole di segnalazione in un processo tipico, noto come fenotipo secretorio associato alla senescenza (SASP).
A prima vista, indurre senescenza cellulare sembrerebbe fornire un percorso terapeutico ideale per il trattamento del cancro, poiché essa interrompe la proliferazione incontrollata associata allo sviluppo del tumore. Molti farmaci antitumorali, così come le radiazioni, sono associati all'induzione della senescenza sia nel tumore che nei tessuti normali, cioè la senescenza indotta dalla terapia o TIS (5).
Tuttavia la TIS (senescenza indotta dalla terapia ) è un'arma a doppio taglio. Alcuni componenti del SASP (fenotipo secretorio associato alla senescenza) sono infatti legati alla promozione dello sviluppo del tumore. La TIS può causare infiammazione cronica e resistenza ai chemioterapici e, a causa della instabilità del genoma delle cellule tumorali, le cellule coinvolte rischiano di sfuggire al processo di senescenza virando verso una crescita incontrollata.
La volontà di risolvere questo dilemma ha portato all'emergere di una nuova classe di farmaci "senolitici": small-molecule (piccole molecole) che colpiscono selettivamente le cellule tumorali senescenti per avviarne la distruzione, tipicamente inducendo apoptosi (6). Questa modalità di terapia potrebbe servire come adiuvante alla chemioterapia tradizionale o alla radioterapia per il trattamento del cancro.
Un candidato promettente per la terapia contro il cancro è il ligando che induce apoptosi correlata al fattore di necrosi tumorale (TRAIL). Questa proteina transmembrana induce apoptosi legandosi ai recettori di morte DR4 e DR5. TRAIL si lega inoltre anche a due recettori esca, DcR1 e DcR2, che non sono però in grado di attivare la via di segnalazione apoptotica (7). Uno studio condotto da due gruppi dell'Università di Groningen, nei Paesi Bassi, ha cercato di determinare la sensibilità delle cellule tumorali senescenti a TRAIL (8).
Utilizzando linee cellulari di carcinoma mammario e ovarico sensibili a TRAIL, i ricercatori hanno indotto la senescenza tramite il farmaco antitumorale doxorubicina. Hanno poi eseguito analisi in qRT-PCR con pannelli di geni associati alla senescenza e al recettore TRAIL per monitorare la senescenza, utilizzando i kit Maxwell® LEV simplyRNA Cells/Tissue per isolare l'RNA. Alle cellule, trattate con TRAIL umano ricombinante, è stata poi misurata la vitalità cellulare. Ciò che i ricercatori hanno potuto osservare è una sensibilità a TRAIL variabile tra le linee cellulari testate. I dati da loro raccolti hanno suggerito come, una maggiore resistenza all'apoptosi, non sia caratteristica comune delle cellule tumorali TIS.
In una seconda fase dello studio, i ricercatori hanno misurato l'attività apoptotica utilizzando Caspase-Glo® 3/7 Assay e monitorato la segnalazione TRAIL attraverso i livelli di espressione di vari recettori TRAIL. Il team ha quindi scoperto come, nonostante il mantenimento delle capacità apoptotiche e l'espressione di livelli più elevati di DR5, alcune cellule tumorali TIS potrebbero acquisire resistenza all'apoptosi indotta dal TRAIL sovraesprimendo vari recettori esca.
Sulla base dell'osservazione di una forte sovraespressione di DR5 ma non di DR4 in cellule senescenti resistenti a TRAIL, i ricercatori hanno cercato di capire se una variante TRAIL selettiva per DR5 potesse aumentare la risposta apoptotica, scoprendo una maggiore attività della variante TRAIL denominata DHER, rispetto a tutte le altre varianti nell'indurre apoptosi nelle cellule tumorali senescenti, (senza per altro mostrare segni di tossicità per le cellule normali). Per confermare questi risultati, i ricercatori hanno utilizzato un modello 3D di sferoidi in senescenza e misurato la vitalità cellulare con il test CellTiter-Glo® 3D, l'attività della caspasi utilizzando il test Caspase-Glo® 3/7 3D e la citotossicità utilizzando il test CellTox™ Green Cytotoxicity. Il tutto ha comprovato l'efficacia di TRAIL DHER nell'eliminazione delle cellule tumorali TIS.
Secondo gli autori di questo prezioso studio, la vulnerabilità acquisita dalle cellule tumorali TIS suggerisce come l'uso della stimolazione selettiva del DR5 possa migliorare le terapie contro il cancro. Non a caso, diverse ricerche con l'obiettivo di indurre apoptosi nelle cellule tumorali TIS stanno prendendo piede. Aumentare la nostra comprensione della senescenza cellulare nel cancro, arrivando ad un conseguente sviluppo di nuove terapie mirate sulle cellule tumorali senescenti potrebbe, nel tempo, sferrare un colpo letale a molti tipi di cancro.
Ti è piaciuto questo articolo? Condividilo!